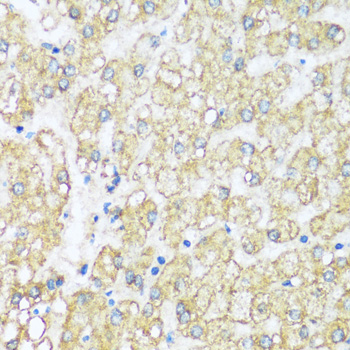
Immunohistochemistry - ATP5I Polyclonal Antibody

-
Product Name
ATP5I Polyclonal Antibody
- Documents
-
Description
Polyclonal antibody to ATP5I
-
Tested applications
IHC
-
Species reactivity
Human
-
Alternative names
ATP5I antibody; ATP5K antibody; ATP synthase subunit e, mitochondrial antibody
-
Isotype
Rabbit IgG
-
Preparation
Antigen: Recombinant fusion protein containing a sequence corresponding to amino acids 1-69 of human ATP5I (NP_009031.1).
-
Clonality
Polyclonal
-
Formulation
PBS with 0.02% sodium azide, 50% glycerol, pH7.3.
-
Storage instructions
Store at -20℃. Avoid freeze / thaw cycles.
-
Applications
IHC 1:50 - 1:200
-
Validations
Immunohistochemistry - ATP5I Polyclonal Antibody
Immunohistochemistry of paraffin-embedded human liver using ATP5I antibody at dilution of 1:100 (40x lens).

Immunohistochemistry - ATP5I Polyclonal Antibody
Immunohistochemistry of paraffin-embedded human breast cancer using ATP5I antibody at dilution of 1:100 (40x lens).

Immunohistochemistry - ATP5I Polyclonal Antibody
Immunohistochemistry of paraffin-embedded human stomach using ATP5I antibody at dilution of 1:100 (40x lens).

Immunohistochemistry - ATP5I Polyclonal Antibody
Immunohistochemistry of paraffin-embedded human uterine cancer using ATP5I antibody at dilution of 1:100 (40x lens).
-
Background
Mitochondrial membrane ATP synthase (F(1)F(0) ATP synthase or Complex V) produces ATP from ADP in the presence of a proton gradient across the membrane which is generated by electron transport complexes of the respiratory chain. F-type ATPases consist of two structural domains, F(1) - containing the extramembraneous catalytic core, and F(0) - containing the membrane proton channel, linked together by a central stalk and a peripheral stalk. During catalysis, ATP synthesis in the catalytic domain of F(1) is coupled via a rotary mechanism of the central stalk subunits to proton translocation. Part of the complex F(0) domain. Minor subunit located with subunit a in the membrane.
Related Products / Services
Please note: All products are "FOR RESEARCH USE ONLY AND ARE NOT INTENDED FOR DIAGNOSTIC OR THERAPEUTIC USE"
